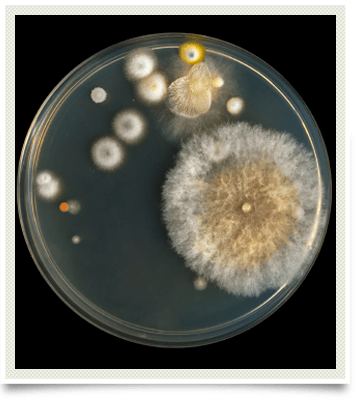

Mycotoxins
Serious and Toxic
Mycotoxins are produced by fungi and are toxic when inhaled or consumed. These can accumulate in the home or in the field. Conditions that favor the growth of mycotoxins are high moisture content, physical damage to stored food, warm to hot temperatures, a humid climate, and drought stressed plants.
Mycotoxins have a very serious effect on the human body. Effects of mycotoxins on organ systems include neuropathy, organ failure, immunosuppression, bone marrow destruction, and cancer.
Molds associated with mycotoxin production include aspergillus, penicillium, cladosporium, fusarium, and mucor. Mycotoxins include aflatoxin, fumonisin, vomitoxin, zearalenone, T-2 toxin (tricothecenes and DAS), and ocratoxin.
Mycotoxin Testing
Mycotoxin testing is available through the office of Dr. Gregg S. Govett. The laboratory is located in a different state and requires prepayment for the testing. It should be noted that the mycotoxin analysis is strictly qualitative (present or not present in the body) and does not assess the level of mycotoxin present in the body.
